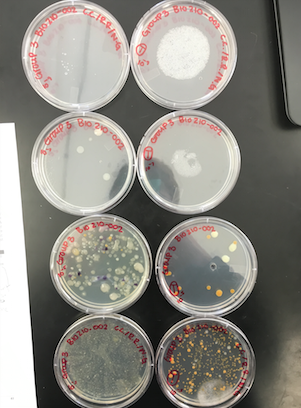
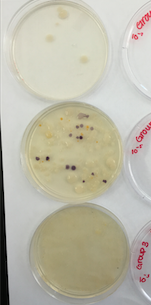

User:Neda M. Ghias/Notebook/Biology 210 at AU
Week 1
Transect 3
Our group has transect three to explore. This transect is located by the bushes by bender arena. Some general characteristics of our transect are we found very little snow powered on the ground and the soil was very frozen. Our transect was covered by lower and higher bushes, trees, benches, and a lamppost. Located around were more bushes and trees. Our first day the weather was sunny and frigid. Some abiotic factors we found were a metal lamppost (1), two benches (2), rocks on the ground (3), soil (4), and some water/snow (5). Some biotic factors we observed were leaves (6), stems of plants (7), roots (8), and branches from trees (9).
Week 2
Our samples collected during week one, from transect 3, were put together to create a Hay Infusion Culture.We created this by putting all our items we collected into a plastic container with powdered milk and water, then we shook it around. After sitting in the classroom temperature for a week we observed them and collected some samples from both the top of the culture (which was from the layer of mold on the top) and the bottom (which was near green plant life). Then we used a microscope to find three different protists from both the top and bottom layers.
This is an image form the top of the Hay Infusion Culture.
This is an image from the bottom of the Hay Infusion Culture
<Br
Some things I observed form the Hay Infusion Culture are the smell. I smelled things such as decomposition, dirt, mold, and dead water from a creek. The appearance was murky water, mold on the top, light brown, and dirt settled at the bottom.
Both of our protists from the bottom and top cultures were the same.
When doing the petri dishes we had to do some calculations because we were diluting them.
If our Hay Infusion Culture were to grow for another two months I would expect there to be a lot more mold found in the water. Also think the water would get a lot more murky and brown. I think if were to collect another sample from two different niches we would definitely find a lot more organisms in the water.
Week 3
Our Hay Infusion Culture from two weeks ago had some slight changes with this being the third week. First we noticed the water a little murkier, darker with more mold around the top, there was discoloration in the plant matter, and also some of the water had evaporated. The smell was almost the same but we noticed it wasn't as strong and smelled more like dirt. The appearance or smell might change from week to week because more bacteria is growing and making more mold to grow and make the water look darker and murkier. Archae species are not able to grow on the agar plates made from the Hay Infusion because the conditions these plates are in are not as extreme as the conditions archae grows in.
Agar Plates
Some differences we observed in the colony types between the plates that have antibiotic vs. don't.
The non- tetracycline have: less orange, but more white and purple. On the 10^-5 plate there was no mold and on 10^-3 there was a lawn.
The tetracycline positive have: a lot more white and orange in 10^-5 plate. There was a lot of mold on 10^-3, but in general less bacteria was found on these ones.
This is the image for yellow/orange:
Week 4
The five plants we chose were:
Number 1 was found between 9 and 4 on the transect map above.
Number 2 was found around location 2.
Number 3 was found around location 7.
Number 4 was found around location 5.
Number 5 was found around location 7.
Below is a description of each of the plants:
Each plant was observed under the microscope:
The leaves we brought back were dark and most dried up. Most were crumbled and mixed with dirt or branches. The size was mostly small and not a defined shape.
From the plants we brought back:
Identifying the type of seeds:
1, 2, and 3. Had some little seeds right on the branches.
4 and 5. Had more like ferns.
Fungi:
The fungi I looked at was a mushroom. As I observed I could see some mold and very defined shape as the outside more smooth and flat.
Week 5
This week we looked at different invertebrates that were in our transect collection we brought back to lab. The Berlese funnels were set up under lights hanging with a funnel into a conical tube to let the organisms fall through. When we look at our Berlese funnels, we only found two invertebrates but they were the same. Using the dichotomous key were came to identify the organisms as termites, believing one of them could be a secondary queen. Using a microscope at 2x we measured the two. The first one we measured was around 50 and the second one was 61.
I believe that these types of organisms along with ticks are the things found in leaf litter. Termites are soft bodied insects. Their abdomen is broadly joined to the thorax and development occurs by simple metamorphosis.
In conclusion, our transect contained bacteria in the soil. Their were both living and non-living plants scattered around the transect and based on each a food web was followed.
Week 6
Zebra Fish Experiment
For the zebra fish experiment we had two different pallets with 24 different holes. We created on as our constant (zebra fish water) and the other one was mixed with NaCl. One egg was placed in each hole. Everyday one of my partners came to check on the zebra fish to make sure each one was filled with enough water. I made my first visit on Monday, February 22. I observed that the eggs in NaCl did not hatch as much there were only two zebra fish. In the constant one, almost all of them had hatched but it was still difficult to see a heart beat.
Week 7
The fish were maintained and the hatched eggs were fed. Two still are living in the NaCl container and the control one had still many living. They are being checked for their height growth each week.
10^-3 Sequence: NNNNNNNNNNGNNGCNNNNNTGCAGTCGAACGGGGTANGCGTAANGCTGCTNCTAGAGGGGGAGAGGGGTGCGTGAGGGC NNAGCGTCTGACTGACCGCGGGAGAGGGGTTGAAANAGGAACGCTAAAACCATGAACGTCACAGAGGAAAAGGCGGGAGA CGGTGGCCTTTTGCTCTATTTAATGATNATGGGTGGGAGCCCGAGANGGTGGTGGTNNTCNCCGTAANGGNAAGATGTAT ATGGGGTCAGAGAANAAGCTNAGACNCAGAGAAACTGAGACAGCGTCCAGACTCATACGGGGGGNGGGTGTGGAATTTGG GGCAATGGGGGAAAGGGCCATATCCAGCCGTGCCGCGTGTGCGAAGAACGCCTGAGTTTTGCCCTGCTTTTTGTCTTGNG ATGAAGGCCAGGAATAAAATATTCTACNCTTGTGATTCTGACTGTACAAAAAGAATAAGGACCGGCTAACTCCGTGCCCG CAGCCGCGGTAATACGGAGGATGCTAGCGTTATTCAGATTTATTGGGTTTAACGCGTGCGTATGCGGTCTTTTAATTCAA TGGTCAAATACTCTACCTCAACTGTCGCATTGCCTTTGATACTGTAGTACTTGAGTCTGTTTGANGTGNGTGCAATTACA CGTGTAACGGTGATATNCATANATATGTCNNGGANCTCCNATTGCGNNNGCCTCTCCCTANNCTNNCACTGACGCTNATG CACGAANGNNNNNGGATCGAACAGGATTACATACNCTCNNNNNCCACNCCCTANACAATTATAACTTGATGTTTGNNAAG ACAAAANNCTNCCCNCCCNCCCCAANCNTTTNNTTNNTNNNCCTNNGGAGGAGGNNCNCCCNGGTGAANACTCNNNNGNN TTTNNNNNCNGNCNNCACNCNCNCANNANNNGNNNNNNNNNNNNNNTNATACNNNAANNAACCNTGCNNCCCCTCCTTNN NNNNNGGGGGNNGNGGANAANNANNNNNNNNNNGNTNNNNNNNNNNANGANGNAANNNNNNNNNGGNGGGGNNNNNNNNN NNNNNNNTNTTNNTANNNNNANNNGGNGNNNNNANCNNCNNNNNGTNNNNN
10^-3 tet Sequence: NNNNNNNNNCNTANNNTGCAGTCGTANCAANGTAGCCNNNNNNTCCTGGCGGCGAGTGGCGAACGGGTGAGTAATACATC GGAACGTGCCCAATCGTGGGGGATAACGCAGCGAAAGCTGTGCTAATACCGCATACGATCTACGGATGAAAGCAGGGGAT CGCAAGACCTTGCGCGAATGGAGCGGCCGATGGCAGATTAGGTAGTTGGTGAGGTAAAGGCTCACCAAGCCTTCGATCTG TAGCTGGTCTGAGAGGACGACCAGCCACACTGGGACTGAGACACGGCCCAAACTCCTACGGGAGGCAGCAGTGGGGAATT TTGGACAATGGGCGAAAGCCTGATCCAGCCATGCCGCGTGCAGGATGAAGGCCTTCGGGTTGTAAACTGCTTTTGTACGG AACGAAACGGCCTTTTCTAATAAAGAGGGCTAATGACGGTACCGTAAGAATAAGCACCGGCTAACTACGTGCCAGCAGCC GCGGTAATACGTAGGGTGCAAGCGTTAATCGGAATTACTGGGCGTAAAGCGTGCGCAGGCGGTTATGTAAGACAGTTGTG AAATCCCCGGGCTCAACCTGGGAACTGCATCTGTGACTGCATAGCTAGAGTACGGTAGAGGGGGATGGAATTCCGCGTGT AGCAGTGAAATGCGTAGATATGCGGAGGAACACCGATGGCGAAGGCAATCCCCTGGACCTGTACTGACGCTCATGCACGA AAGCGTGGGGAGCAAACAGGATTAGATACCCTGGTAGTCCACGCCCTAAACGATGTCAACTGGTTGTTGGGTCTTCACTG ACTCANTAACNAAGCTAACGCGTGAAGTTGACCGCCTGGGGAGTACGGCCGCAAGGTTGAAACTCAAGGAATTGACGGGG ACCCGCACNAACGGTGGATGATGTGGTTTAATTCNATGCAACNCNAAAAACCTTACCCACCTTTGACATGTACGGAATTC NNCAGANNTNGCTTANGGCTCNAANNANAACCGTTACACNGNTGCTGCATGGNNGTCNTCAGCTCGTGTCNNGAGNNNNT NGGGNTAANTCCCGNAACNAGCNCNNACCCNNTGNNN